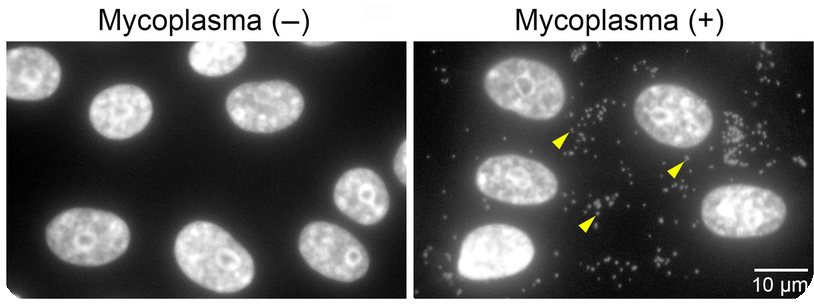

Mycoplasma Testing in Biologic Manufacturing: Market Dynamics and Technical Essentials
Introduction
Mycoplasma contamination represents one of the most insidious threats in biologic drug manufacturing, and the testing services market addressing this challenge has become increasingly valuable as cell-based therapies proliferate. These cell wall-deficient bacteria can persist undetected in cell culture systems for extended periods, compromising product quality, safety, and efficacy while potentially invalidating months of manufacturing effort and millions of dollars in product value.
The mycoplasma testing market is experiencing robust growth driven by expanding biologics manufacturing, increasing regulatory scrutiny, and the shift toward rapid molecular testing methods. For technical professionals, understanding mycoplasma testing requirements is critical for ensuring product quality and regulatory compliance. For investors and business strategists, the mycoplasma testing services sector represents a compelling opportunity at the intersection of mandatory regulatory testing, technological innovation, and the explosive growth of cell and gene therapies.
This guide examines the unique challenges mycoplasma pose, available detection methods and their market adoption, regulatory drivers creating sustained demand, and the competitive landscape shaping this specialized testing segment.
- The global mycoplasma testing market is projected to reach $1.2+ billion by 2030, driven by biologics and cell therapy growth
- Mycoplasma contamination can evade traditional sterility testing, creating mandatory demand for specialized testing services
- Rapid PCR-based testing methods are displacing traditional culture-based approaches, reshaping competitive dynamics
- Historical contamination incidents causing production shutdowns demonstrate the financial imperative for robust testing
- Cell therapy and gene therapy manufacturing represents the fastest-growing segment for mycoplasma testing demand
Understanding Mycoplasma: Technical Characteristics and Business Implications
Mycoplasma are among the smallest self-replicating organisms, typically measuring 0.2 to 0.3 micrometers in diameter. Their defining characteristic is the complete absence of a cell wall, a feature that fundamentally shapes their biology, detection challenges, and the business opportunity in specialized testing services.
The lack of a cell wall renders mycoplasma insensitive to beta-lactam antibiotics such as penicillin and cephalosporins that target cell wall synthesis. This antibiotic resistance, combined with their small size allowing passage through standard 0.22-micron sterilizing-grade filters, makes mycoplasma particularly problematic in manufacturing environments. Their slow growth characteristics and ability to form biofilms further complicate detection and elimination efforts.
From a business perspective, these unique characteristics create several important market dynamics. First, mycoplasma testing cannot be adequately addressed by traditional sterility testing services, necessitating specialized testing capabilities and creating a distinct market segment. Second, the technical complexity of mycoplasma testing creates barriers to entry that support pricing power for established service providers. Third, the consequences of contamination are severe enough that manufacturers prioritize testing reliability over cost, creating a quality-driven rather than price-driven market.
Over 200 mycoplasma species have been identified, but relatively few are commonly encountered in cell culture contamination. Mycoplasma orale, Mycoplasma hyorhinis, Mycoplasma arginini, Mycoplasma fermentans, and Acholeplasma laidlawii account for the majority of documented contamination events in biopharmaceutical manufacturing. Understanding the specific species distribution is valuable for testing service providers in validating detection methods and for manufacturers in conducting contamination investigations.
Market Drivers and Growth Dynamics
The mycoplasma testing market is experiencing sustained growth driven by multiple converging factors that create a compelling investment thesis alongside technical imperatives for manufacturers.
Biologics and Biosimilars Expansion

The global biologics market exceeded $400 billion in 2024 and continues to grow at 8-10% annually. Monoclonal antibodies alone represent over $200 billion in annual sales, with hundreds of candidates in development pipelines. Every biologics manufacturing campaign utilizing mammalian cell culture requires mycoplasma testing at multiple points, creating a direct correlation between biologics market growth and testing demand.
Biosimilars development further amplifies testing demand. As biologics patents expire, dozens of companies are developing biosimilar versions, each requiring comprehensive analytical characterization including mycoplasma testing. Unlike small molecule generics, biosimilars cannot rely solely on chemical equivalence but must demonstrate comparability through extensive testing programs that include adventitious agent testing.
The shift toward continuous manufacturing in biologics production creates additional testing demand. Continuous perfusion systems can run for weeks or months, with periodic mycoplasma testing required to ensure ongoing process control. This generates recurring testing revenue from individual manufacturing campaigns, unlike traditional batch processes where testing occurs only at defined campaign endpoints.
Cell and Gene Therapy Market Emergence

Cell and gene therapies represent the fastest-growing segment driving mycoplasma testing demand. The global cell therapy market is projected to exceed $30 billion by 2030, with approved products expanding beyond hematologic malignancies into solid tumors, autoimmune diseases, and regenerative medicine applications.
These advanced therapies face particularly stringent mycoplasma testing requirements given their direct administration to patients without terminal sterilization. Testing is typically required for starting materials, intermediate manufacturing stages, and final products, multiplying the testing burden per manufacturing campaign compared to traditional biologics. For autologous cell therapies where each patient represents a separate manufacturing campaign, the cumulative testing demand is substantial.
The compressed timelines characteristic of autologous cell therapy manufacturing have driven rapid adoption of fast PCR-based testing methods, creating opportunities for service providers offering validated rapid testing capabilities. Traditional culture-based testing requiring up to 28 days is incompatible with 2-3 week manufacturing timelines for many cell therapy products, necessitating investment in rapid methods and creating competitive differentiation for service providers with appropriate capabilities.
Regulatory Drivers and Enforcement

Regulatory requirements create mandatory, non-discretionary demand for mycoplasma testing that is largely immune to economic cycles. FDA, EMA, and other regulatory agencies require mycoplasma testing for all biologics manufactured using cell culture systems, with specific requirements codified in pharmacopeial chapters and guidance documents.
Regulatory enforcement has intensified following notable contamination incidents. FDA warning letters increasingly cite mycoplasma testing deficiencies, including inadequate method validation, inappropriate testing frequencies, and failure to investigate atypical results. This regulatory scrutiny drives manufacturers toward more comprehensive testing programs and creates demand for expert testing services that can withstand regulatory inspection.
The evolving regulatory landscape also creates market opportunities. As agencies gain experience with rapid molecular testing methods, regulatory acceptance of these approaches is expanding. Service providers that invest in validating novel testing platforms and can demonstrate regulatory acceptability gain competitive advantages in markets where speed is increasingly valued.
Geographic Market Expansion

While North America and Europe currently dominate mycoplasma testing services consumption, Asia-Pacific markets are experiencing rapid growth. China, India, South Korea, and Singapore are building substantial biologics manufacturing capacity, with local and multinational companies establishing production facilities. These emerging manufacturing hubs require mycoplasma testing services, creating opportunities for both established multinational service providers and regional competitors.
The regulatory maturation in these markets is driving increased testing rigor. As regulatory agencies in emerging markets align with ICH standards and implement more stringent biologics oversight, manufacturers in these regions are adopting testing practices comparable to Western markets, expanding the addressable market for testing services.
Why Traditional Sterility Testing Fails: Technical Gap and Service Opportunity
The United States Pharmacopeia chapters on sterility testing (USP <71>) establish standard methods for detecting microbial contamination in pharmaceutical products. However, these traditional sterility tests are notoriously unreliable for detecting mycoplasma contamination, creating both a technical challenge for manufacturers and a market opportunity for specialized testing service providers.
Several fundamental characteristics of mycoplasma explain this detection gap and justify the premium pricing that specialized mycoplasma testing commands. First, mycoplasma grow extremely slowly compared to conventional bacteria, often requiring weeks rather than days to reach detectable levels in culture media. Standard sterility testing protocols typically employ 14-day incubation periods, which may be insufficient for mycoplasma detection depending on the initial contamination level and specific species involved.
Second, mycoplasma have complex nutritional requirements that are not always met by standard sterility testing media. Many mycoplasma species require sterols for membrane synthesis and specific nutrients not present in conventional bacteriological media. This necessitates specialized media formulations and culture conditions that are distinct from routine sterility testing, creating a technical barrier that supports the specialized testing services market.
Third, the small colony size and morphology of mycoplasma on solid media make visual detection challenging, requiring specialized microscopy capabilities and trained personnel. This expertise requirement represents a significant competitive moat for established testing service providers, as building the necessary technical capabilities requires substantial investment and time.
From a business perspective, the inadequacy of sterility testing for mycoplasma detection creates several important market characteristics. The testing represents a regulatory requirement that cannot be substituted with existing capabilities, creating mandatory incremental spending for manufacturers. The technical complexity supports pricing power for service providers with validated methods and regulatory track records. The consequences of testing failures are severe enough that manufacturers prioritize reliability over cost, creating a market less sensitive to price competition than many other testing segments.
Regulatory Framework and Compliance Market
The regulatory requirements for mycoplasma testing are established through multiple United States Pharmacopeia chapters, FDA guidance documents, and international harmonization efforts. Understanding this framework is essential both for manufacturers developing compliant testing strategies and for investors evaluating the durability of testing demand.
USP <63> “Mycoplasma Testing” represents the primary compendial chapter establishing acceptable methods for mycoplasma detection. This chapter describes both culture-based methods and nucleic acid amplification techniques (NAT), providing detailed protocols, media formulations, and acceptance criteria. The chapter was significantly revised in 2019-2020 to incorporate rapid molecular methods alongside traditional culture-based approaches, reflecting technological advances in the field and creating market opportunities for service providers with validated rapid testing capabilities.
The incorporation of rapid methods into USP <63> represents a significant market inflection point. Prior to this revision, molecular methods were considered alternative methods requiring extensive validation to demonstrate equivalence to compendial approaches. The explicit inclusion of NAT methods in the compendial chapter provides a clearer regulatory pathway for adoption, accelerating the market shift toward rapid testing and rewarding service providers that invested early in these capabilities.
USP <1043> “Ancillary Materials for Cell, Gene, and Tissue-Engineered Products” provides guidance on testing ancillary materials that contact cells during manufacturing. This chapter emphasizes mycoplasma testing of raw materials, particularly those of animal or human origin, and recommends testing master and working cell banks. The guidance creates additional testing touchpoints beyond final product testing, expanding the total addressable market for testing services.
For advanced therapy medicinal products including cell and gene therapies, additional guidance is provided through documents such as FDA’s guidance on gene therapy products and various European Medicines Agency guidelines. These documents emphasize the critical importance of mycoplasma testing for products that will be directly administered to patients without terminal sterilization, creating heightened testing requirements and supporting premium pricing for testing services serving this segment.
The International Council for Harmonisation (ICH) has worked to align mycoplasma testing requirements globally, though regional variations persist in specific testing scenarios. This harmonization benefits multinational service providers with capabilities to support testing under multiple regulatory frameworks, creating competitive advantages over regional providers with more limited regulatory expertise.
From an investment perspective, the regulatory framework creates several attractive market characteristics. The mandatory nature of testing creates stable, predictable demand that is largely immune to economic cycles. The regular updates to compendial chapters and guidance documents create ongoing opportunities for service providers that invest in new capabilities aligned with regulatory evolution. The global regulatory harmonization efforts expand the addressable market for service providers with appropriate multi-regional capabilities.
Mycoplasma Testing Methods: Technology Evolution and Market Impact
Organizations must select mycoplasma testing methods based on product characteristics, manufacturing timelines, regulatory expectations, and available resources. The evolution of testing technologies is reshaping the competitive landscape and creating distinct opportunities for different service provider business models.
Culture-Based Direct Detection: Declining but Persistent Market
The culture-based direct detection method involves inoculating test samples onto selective mycoplasma agar media and into enrichment broth, followed by incubation at 35-37°C in 5-10% CO2 atmosphere for up to 28 days. This represents the traditional gold standard mycoplasma testing approach, with decades of regulatory acceptance and extensive validation data.
Despite technological advances, culture-based testing retains significant market share driven by regulatory conservatism and the method’s ability to detect viable mycoplasma across a broad range of species. Many contract development and manufacturing organizations (CDMOs) and established pharmaceutical companies maintain culture-based testing capabilities as primary or confirmatory methods, creating sustained demand for testing services offering these capabilities.
However, the culture-based testing market is declining as manufacturers adopt rapid methods. The 28-day incubation period is incompatible with compressed product development timelines and increasingly rapid manufacturing campaigns. For service providers, culture-based testing ties up laboratory capacity for extended periods, limiting throughput and creating operational challenges in scaling to meet market demand.
The economics of culture-based testing favor large, established service providers with significant testing volumes that can absorb the fixed costs of specialized facilities and trained personnel. Smaller providers may struggle to maintain profitability given the extended testing timelines and specialized expertise requirements. This creates market consolidation pressure and may drive acquisition opportunities as larger providers seek to expand capacity.
Nucleic Acid Testing (NAT): High-Growth Market Segment
PCR-based NAT methods have revolutionized mycoplasma testing by providing rapid, sensitive, and specific detection. These methods amplify mycoplasma-specific genetic sequences (typically 16S ribosomal RNA genes) allowing detection within hours rather than days or weeks. Commercial kits are available from multiple vendors, many with regulatory acceptance for use in GMP environments.
The NAT testing market is experiencing robust growth exceeding 15% annually, driven by cell therapy adoption, manufacturing timeline compression, and expanding regulatory acceptance. Service providers offering validated rapid testing capabilities command premium pricing relative to culture-based methods, with typical test pricing ranging from $500-1500 per sample depending on turnaround time, volume, and complexity.
From a business model perspective, NAT methods offer several advantages for testing service providers. The rapid turnaround enables higher laboratory throughput, allowing more tests per unit of laboratory capacity and improving capital efficiency. The method’s standardization through commercial kit platforms reduces operator-dependent variability and training requirements, facilitating geographic expansion and capacity scaling. The growing regulatory acceptance reduces validation burden for service providers implementing NAT methods.
However, NAT methods also create competitive dynamics that may pressure margins over time. The reliance on commercial kit platforms reduces differentiation among service providers, potentially commoditizing the testing service. Equipment costs for real-time PCR systems are moderate, lowering barriers to entry for new service providers. The short testing timelines may compress pricing as competition intensifies, though quality requirements and validation burdens still provide substantial barriers to new entrants.
Leading testing service providers are differentiating through additional value-added services including method optimization for specific sample types, contamination investigation support, regulatory filing assistance, and integration with broader testing panels. These services create switching costs and support premium pricing beyond commodity testing.
Technology Platform Providers: Equipment and Reagent Market
The shift toward molecular testing has created a parallel market opportunity in testing platforms, reagents, and kits. Companies such as Lonza (MycoAlert), Thermo Fisher Scientific, Merck KGaA, and specialized providers like Charles River Laboratories offer commercial mycoplasma testing solutions targeting both in-house testing laboratories and contract testing service providers.
This market segment has distinct competitive dynamics from testing services. Platform providers benefit from recurring reagent revenue as customers conduct ongoing testing, creating an attractive revenue model with consumables tied to installed equipment base. Regulatory acceptance of platforms creates significant switching costs, as replacing a validated testing method requires extensive revalidation work.
However, platform providers face commoditization risk as multiple suppliers offer comparable PCR-based solutions. Differentiation increasingly depends on factors such as detection speed, multiplexing capability (simultaneous detection of multiple contaminants), ease of use, and integration with laboratory automation systems. Companies that can offer comprehensive contamination testing panels detecting mycoplasma alongside other adventitious agents may capture greater market share than single-analyte providers.
The total addressable market for testing platforms and reagents is substantial, with biologics manufacturers, cell therapy developers, and research institutions representing customers alongside contract testing service providers. However, pricing pressure from competitive intensity and customer purchasing power may constrain margin expansion in this segment.
Emerging Technologies: Future Market Opportunities
Several emerging technologies are being evaluated for mycoplasma detection, creating potential disruption opportunities for innovative companies and investors. Next-generation sequencing approaches can detect mycoplasma while simultaneously characterizing the complete microbial community in samples, providing comprehensive contamination assessment beyond single-analyte testing.
Digital PCR represents another emerging technology offering absolute quantification without standard curves and potentially improved sensitivity. While adoption in routine mycoplasma testing remains limited, the technology may find applications in contamination investigations, process monitoring, or other specialized scenarios justifying premium pricing.
Biosensor technologies and microfluidic platforms promise even more rapid detection with minimal sample preparation and reduced equipment costs. However, these technologies face significant validation and regulatory acceptance hurdles before achieving substantial market adoption. Companies investing in these platforms are making long-term strategic bets that may create significant competitive advantages if successful but carry substantial execution risk.
For investors, emerging technology companies in this space represent higher-risk, higher-return opportunities compared to established testing service providers. The potential to disrupt existing testing paradigms and capture market share from incumbents is attractive, but the regulatory and technical challenges of introducing novel testing methods should not be underestimated.
Products Requiring Mycoplasma Testing: Market Segmentation
Regulatory agencies require mycoplasma testing for products manufactured using cell culture systems or containing materials derived from such systems. Understanding market segmentation by product type provides insight into growth drivers and opportunities within the mycoplasma testing market.
Biologics and Biosimilars: Largest Current Market

Monoclonal antibodies, recombinant proteins, and biosimilar products manufactured in mammalian cell culture systems represent the largest current market for mycoplasma testing services. This segment benefits from both the large installed base of approved biologics requiring ongoing manufacturing support and the substantial development pipelines creating new testing demand.
Image source: Totten, Arthur & Adams, Anna & Halas, Hyunmi & Gebo, James & East, Amanda & Lau, Anna. (2023). Comparison of Five Commercial Molecular Assays for Mycoplasma Testing of Cellular Therapy Products. Journal of Clinical Microbiology. 61. 10.1128/jcm.01498-22.
Testing for this segment typically includes cell bank characterization (master and working cell banks), end-of-production cells or culture harvest, and in some cases the final drug substance or product. Large-scale commercial manufacturing campaigns can generate dozens of mycoplasma tests per batch across multiple testing points, creating substantial recurring revenue for testing service providers.
The market dynamics in this segment favor established contract research organizations and testing service providers with long regulatory track records and relationships with major pharmaceutical companies. The conservative nature of biologics manufacturing means customers prioritize reliability and regulatory acceptability over cost, supporting relatively stable pricing despite competitive intensity.
From an investor perspective, this segment offers stable, predictable growth tied to overall biologics market expansion. However, the mature nature of the segment and established competitive landscape may limit opportunities for significant market share gains or margin expansion absent significant technological differentiation.
Cell and Gene Therapies: Highest Growth Segment
Advanced therapy medicinal products face particularly stringent mycoplasma testing requirements given their direct administration to patients without terminal sterilization. This segment is experiencing the highest growth rate within mycoplasma testing, with market expansion exceeding 20% annually driven by increasing product approvals and expanding manufacturing activity.
Image source: Bamba, Kenzo & Takabe, Kyosuke & Daitoku, Hiroaki & Tanaka, Yoshikazu & Ohtani, Azusa & Ozawa, Midori & Fukamizu, Akiyoshi & Nomura, Nobuhiko & Kohara, Arihiro & Kunoh, Tatsuki. (2023). Discrimination of mycoplasma infection using machine learning models trained on autofluorescence signatures of host cells. Sensors & Diagnostics. 3. 10.1039/d3sd00175j.
The testing requirements for cell and gene therapies are more extensive than traditional biologics, with testing typically required for starting materials (particularly primary cells), intermediate manufacturing stages, and final products. For autologous cell therapies where each patient represents a separate manufacturing campaign, the cumulative testing demand substantially exceeds that of traditional biologics manufacturing.
The compressed timelines characteristic of autologous cell therapy manufacturing have driven rapid adoption of fast PCR-based testing methods in this segment. Service providers offering validated rapid testing with results available within 24-48 hours command significant pricing premiums, with some providers charging 2-3x the pricing of standard testing given the value proposition of enabling faster product release.
This segment presents attractive opportunities for both specialized cell therapy testing service providers and established players expanding into this market. The technical complexity and regulatory requirements create barriers to entry that support pricing power. The market is still consolidating, with M&A activity potentially creating value for investors in testing service companies positioned in this segment.
Vaccines: Steady Demand Segment

Vaccines manufactured in cell culture systems require mycoplasma testing of cell substrates and at appropriate manufacturing stages. This segment generates steady testing demand tied to both seasonal vaccine production (influenza vaccines) and pandemic preparedness efforts.
The COVID-19 pandemic highlighted the critical importance of rapid vaccine development and manufacturing scale-up, driving investments in vaccine manufacturing capacity that create ongoing mycoplasma testing demand. The expansion of novel vaccine platforms including mRNA vaccines (though many are manufactured cell-free) and viral vector vaccines (requiring cell culture production) may expand testing opportunities in this segment.
From a market perspective, vaccine testing is characterized by large manufacturing campaigns with substantial testing volumes, but often with more aggressive pricing given the cost-sensitive nature of vaccine economics. Service providers may accept lower per-test margins on vaccine contracts given the volume potential and relative predictability of demand.
Raw Materials Testing: Expanding Opportunity

Serum, growth factors, enzymes, and other raw materials of animal or human origin that contact cells during manufacturing require appropriate mycoplasma testing. This creates a parallel testing market beyond finished products, with manufacturers either conducting in-house testing or outsourcing to specialized service providers.
The increasing adoption of chemically defined, serum-free media in biologics manufacturing may reduce mycoplasma testing demand for some raw material categories. However, the proliferation of complex raw materials including growth factors, cytokines, and specialized reagents for cell therapy manufacturing creates offsetting demand. Additionally, regulatory expectations for raw material testing are intensifying, potentially expanding the testing burden even as specific material categories shift.
Raw material testing services represent an attractive market segment for testing service providers given the recurring nature of demand and potential for long-term supply agreements with manufacturers and raw material suppliers. The ability to offer comprehensive raw material testing panels addressing multiple contamination risks creates differentiation and supports value-based pricing.
Notable Mycoplasma Contamination Incidents: Financial Impact and Market Lessons
The biopharmaceutical industry has experienced numerous mycoplasma contamination events that illustrate both the serious consequences of inadequate contamination control and the compelling financial justification for robust testing programs. These incidents provide important context for understanding customer purchasing behavior in the mycoplasma testing market.
Genzyme Allston Facility (2009): Multi-Hundred Million Dollar Impact
One of the most significant mycoplasma contamination incidents occurred at Genzyme’s Allston, Massachusetts facility in 2009, affecting production of Cerezyme and Fabrazyme, enzyme replacement therapies for rare genetic diseases. While initially attributed to vesivirus contamination, subsequent investigation revealed concurrent mycoplasma contamination in production areas.
The incident resulted in a production shutdown lasting several months, creating critical shortages for patients dependent on these life-sustaining therapies. From a financial perspective, the impact was devastating: Genzyme experienced revenue losses exceeding $400 million in 2010, faced costs exceeding $100 million for facility remediation and validation, confronted hundreds of millions in accelerated payments to competitors for alternative supply, and suffered long-term reputational damage affecting business development and partnerships.
The FDA issued a warning letter citing multiple deficiencies in contamination control and environmental monitoring. The company faced intense scrutiny from patient advocacy groups, regulatory agencies, and the investment community. The contamination incident was cited as a contributing factor in Sanofi’s eventual $20 billion acquisition of Genzyme, with the company’s weakened negotiating position following the crisis potentially reducing acquisition valuation.
For the mycoplasma testing market, the Genzyme incident provides a compelling case study demonstrating the catastrophic financial consequences of contamination events. The cost of robust testing programs and contamination control measures is trivial compared to the potential impact of a production shutdown. This creates a strong value proposition for testing service providers and justifies premium pricing for reliable, validated testing services.
Undisclosed Manufacturing Contaminations: Recurring Market Driver
While many contamination events remain confidential due to competitive concerns, FDA warning letters and inspection observations periodically reference mycoplasma contamination findings. Industry sources estimate that significant mycoplasma contamination events requiring manufacturing campaign termination occur in 1-2% of biologics manufacturing runs annually, with investigation and remediation costs typically ranging from $500,000 to several million dollars per incident.
Even contamination events limited to development activities rather than GMP manufacturing result in lost time, wasted resources, and potential delays in program timelines. For companies in late-stage development racing toward regulatory approval and market launch, even a 3-6 month delay from contamination-related issues can represent tens or hundreds of millions in delayed revenue.
These recurring contamination incidents create sustained demand for testing services and drive customers toward more comprehensive testing programs rather than minimum compliance approaches. The financial consequences of contamination far exceed incremental testing costs, leading rational procurement decisions to prioritize testing reliability over cost minimization.
Market Implications and Customer Behavior
The financial impact of contamination incidents shapes customer behavior in the mycoplasma testing market in several important ways. First, customers demonstrate strong preference for established service providers with extensive regulatory track records and low failure rates, even when premium pricing is required. The reputational risk of selecting a lower-cost provider with less proven capabilities outweighs potential cost savings.
Second, contamination incidents drive demand for rapid testing methods despite higher per-test pricing. The ability to detect contamination early in a manufacturing campaign, before substantial value is added, substantially reduces the financial impact of contamination events. This creates willingness to pay premium pricing for testing services offering faster turnaround times.
Third, manufacturers increasingly adopt redundant testing strategies using multiple methods or service providers to reduce false negative risk. While this increases total testing costs, the redundancy provides additional confidence in results and reduces the probability of contamination events evading detection.
For investors evaluating the mycoplasma testing market, understanding these customer behaviors is critical. The market is not primarily price-driven but rather value-driven, with customers willing to pay for reliability, speed, and expertise. This supports healthy margins for well-positioned service providers and creates opportunities for differentiation beyond pricing competition.
Manufacturing Challenges and Service Provider Opportunities
Beyond their detection challenges, mycoplasma create multiple manufacturing complications that distinguish them from conventional microbial contaminants. These challenges create service opportunities for companies offering comprehensive contamination control solutions beyond basic testing.
Impact on Cell Culture Performance and Product Quality
Mycoplasma can profoundly affect mammalian cell culture systems even at low contamination levels, with infected cells exhibiting altered metabolism, changed growth characteristics, modified protein expression patterns, and increased chromosomal aberrations. These changes can compromise product quality attributes including glycosylation patterns, protein folding, and post-translational modifications.
For manufacturers, the potential for subtle product quality defects from mycoplasma contamination creates substantial regulatory risk. Products manufactured from contaminated cultures could potentially reach patients before quality impacts are detected, creating patient safety concerns and liability exposure. This drives demand not just for end-product testing but for in-process monitoring and rapid detection capabilities that can identify contamination before product quality is affected.
Service providers that can offer rapid testing with results available during manufacturing campaigns rather than only after campaign completion provide substantial value to customers. This creates opportunities for premium pricing on expedited testing services and for integrated contamination monitoring programs that combine testing with consulting on contamination control strategies.
Difficult Eradication and Remediation Services
Once mycoplasma contamination is established in a manufacturing area, eradication can be extremely challenging. The organisms form biofilms on surfaces, penetrate porous materials, and can survive in unexpected environmental niches. Standard cleaning agents and disinfectants may have limited efficacy against mycoplasma, particularly organisms embedded in biofilms.
This creates service opportunities for companies offering contamination investigation, remediation consulting, and environmental monitoring services. The specialized expertise required for effective mycoplasma remediation supports premium pricing, with contamination investigation and remediation projects often generating $100,000+ in consulting revenue beyond basic testing services.
For testing service providers, contamination incidents create both immediate revenue opportunities (intensive environmental and product testing during investigations) and longer-term recurring revenue (enhanced monitoring programs following contamination events). The ability to offer comprehensive contamination solutions including testing, investigation support, and remediation consulting creates differentiation and supports higher customer lifetime value.
Environmental Monitoring Services: Emerging Revenue Stream
While mycoplasma testing of products and materials represents the core market, environmental monitoring programs provide an additional revenue stream. Periodic monitoring of classified manufacturing areas, equipment surfaces, and critical utilities can detect contamination before product impact occurs, though specialized approaches are required given mycoplasma’s unique characteristics.
Environmental mycoplasma monitoring presents both technical challenges and market opportunities. Standard environmental monitoring methods may not reliably detect mycoplasma, necessitating specialized approaches. However, regulatory expectations for environmental monitoring are increasing, and manufacturers are implementing more comprehensive programs following contamination incidents.
Service providers offering validated environmental monitoring programs specifically designed for mycoplasma detection can charge premium pricing relative to standard environmental monitoring services. The recurring nature of environmental monitoring creates predictable revenue streams, and customers typically maintain environmental monitoring programs for extended periods once implemented, providing revenue stability.
Competitive Landscape and Market Structure
The mycoplasma testing services market exhibits a moderately consolidated structure with several large, established players alongside numerous regional and specialized providers. Understanding competitive dynamics is essential for both service providers developing business strategies and investors evaluating market opportunities.
Major Testing Service Providers
Several large contract research organizations and testing service providers dominate the mycoplasma testing market. Charles River Laboratories, with extensive biologics testing capabilities and global laboratory network, represents one of the largest players. Lonza, through both testing services and proprietary testing platforms (MycoAlert), maintains significant market share. Eurofins Scientific, SGS, and other large testing conglomerates offer mycoplasma testing as part of comprehensive biologics testing portfolios.
These large providers benefit from several competitive advantages including established relationships with major pharmaceutical and biotechnology companies, extensive regulatory experience and inspection track records, global laboratory networks enabling multi-regional support, broad testing capabilities allowing bundled service offerings, and significant financial resources for investing in new testing technologies and capacity expansion.
However, large providers may face challenges including organizational complexity limiting responsiveness to customer needs, pricing pressure from procurement departments at large pharmaceutical companies, and difficulty differentiating services in what can become a commodity testing market.
Specialized and Regional Providers
Numerous smaller, specialized providers focus on mycoplasma testing and related contamination control services. These companies often differentiate through specialized expertise in specific product types (cell therapies, viral vectors), exceptional customer service and responsiveness, proprietary testing methodologies or platforms, or strong regional presence and relationships.
Specialized providers may achieve higher margins than large providers on comparable services through premium pricing justified by expertise and service quality. However, they face challenges including limited geographic reach constraining addressable market, capacity constraints limiting ability to handle large programs, and potential difficulty competing for major pharmaceutical company business where procurement processes favor large, established providers.
From an investment perspective, specialized providers may represent attractive acquisition targets for larger companies seeking to enhance capabilities, expand geographic presence, or acquire expertise in high-growth segments such as cell therapy testing.
Technology Platform Companies
Companies offering mycoplasma testing platforms, reagents, and kits represent a parallel competitive segment. Lonza (MycoAlert system), Thermo Fisher Scientific, Merck KGaA, and others compete in this market, with business models based on equipment sales and recurring reagent revenue.
Platform providers face different competitive dynamics than service providers, with product standardization enabling broader market reach but also intensifying price competition. Successful platform companies typically require strong intellectual property positions, regulatory acceptance of platforms creating switching costs, and comprehensive customer support capabilities.
Market Consolidation Trends
The mycoplasma testing services market is experiencing gradual consolidation driven by several factors. Large testing service companies are acquiring smaller specialized providers to expand capabilities and geographic reach. Technology platform companies are acquiring testing service businesses to ensure market access for platforms. Private equity investors are acquiring profitable testing service providers and consolidating them into larger platforms to achieve operating leverage and market power.
This consolidation creates both opportunities and challenges for market participants. Service providers with differentiated capabilities, strong customer relationships, and presence in high-growth segments may command attractive acquisition valuations. However, increasing competitive intensity from larger, better-capitalized competitors may pressure margins for providers unable to differentiate beyond commodity testing services.
Investment Considerations and Market Outlook
For investors evaluating opportunities in the mycoplasma testing market, several factors merit consideration in assessing both the overall market attractiveness and specific investment opportunities.
Market Growth Drivers and Sustainability
The fundamental growth drivers for mycoplasma testing are robust and sustainable. Biologics market expansion creates direct, correlated growth in testing demand, with the relationship between biologics manufacturing volume and testing requirements relatively stable. Cell and gene therapy emergence provides accelerating growth, with this segment experiencing the highest growth rates and premium pricing.
Regulatory requirements create mandatory, non-discretionary demand that is largely immune to economic cycles. Unlike discretionary research spending or early-stage development activities that may contract during economic downturns, mycoplasma testing for commercial manufacturing and late-stage development continues regardless of macroeconomic conditions.
The technological evolution from culture-based to molecular testing methods creates market expansion opportunities. Faster testing enables more frequent testing and in-process monitoring, potentially increasing the total number of tests performed per manufacturing campaign. New testing modalities and complementary services (contamination investigations, environmental monitoring) expand the total addressable market beyond basic compliance testing.
Margin Dynamics and Pricing Power
The mycoplasma testing market demonstrates relatively healthy margins driven by technical complexity, regulatory requirements creating customer preference for reliability over cost, and consequences of testing failures supporting value-based pricing. Established service providers with strong regulatory track records can maintain gross margins in the 45-60% range on testing services, with specialized services commanding even higher margins.
However, several factors may pressure margins over time. Increasing adoption of commercial testing kits may commoditize testing services by reducing technical differentiation among service providers. Growing competitive intensity, particularly from lower-cost regional providers in emerging markets, may create pricing pressure. Customer consolidation in the pharmaceutical industry increases buyer power and may lead to more aggressive procurement practices.
Service providers can defend margins through differentiation strategies including specialized expertise in high-complexity products, value-added services beyond commodity testing, integrated contamination control solutions, and geographic expansion accessing markets with less competitive intensity. The most successful providers will likely be those that evolve from commodity testing services to comprehensive contamination control partners.
Capital Requirements and Scalability
The mycoplasma testing services business exhibits moderate capital intensity. Laboratory facility requirements include appropriate biosafety containment (typically BSL-2), specialized incubation equipment for culture-based methods, and molecular biology equipment for PCR-based methods. Total capital investment for a basic mycoplasma testing laboratory typically ranges from $500,000 to $2 million depending on testing volume, methods offered, and facility requirements.
However, scaling capacity requires not just capital but also trained personnel, method validation, and regulatory qualification. The timeline from deciding to expand capacity to achieving full operational capability typically ranges from 12-24 months, creating barriers to rapid capacity expansion and potential supply constraints during periods of high demand.
From an investment perspective, the moderate capital requirements mean that specialized testing service providers can achieve attractive returns on invested capital if customer acquisition is effective and utilization rates are maintained. However, the challenges of rapid scaling may limit the ability of smaller providers to capitalize on market growth opportunities without significant capital investment.
Regulatory Risk and Opportunity
Changes in regulatory requirements represent both risks and opportunities for the mycoplasma testing market. Regulatory agencies periodically update compendial chapters and guidance documents, potentially creating obsolescence risk for established testing methods or creating advantages for providers that have invested in new approaches.
However, the conservative nature of pharmaceutical regulation means changes typically occur gradually with extended transition periods, limiting disruption risk. Additionally, regulatory changes often expand rather than contract testing requirements, creating market expansion opportunities for service providers positioned to meet new expectations.
The regulatory acceptance of rapid molecular methods represents a significant positive development for the market, expanding the addressable opportunity for PCR-based testing services and creating growth opportunities for service providers with validated rapid testing capabilities.
Strategic Recommendations
For manufacturers, developing robust mycoplasma testing strategies requires balancing regulatory compliance, contamination risk management, manufacturing efficiency, and cost considerations. Key recommendations include implementing risk-based testing programs that identify critical testing points based on contamination probability and impact, adopting rapid testing methods where manufacturing timelines demand faster results, establishing relationships with multiple testing service providers to ensure capacity and reduce single-provider dependency, and investing in contamination prevention rather than relying solely on detection.
For testing service providers, succeeding in the evolving market requires differentiation beyond commodity testing through specialized expertise, exceptional service quality, technological leadership, or integrated solutions. Strategic priorities should include investing in rapid testing capabilities to serve high-growth cell therapy segment, developing comprehensive contamination control solutions beyond basic testing, expanding geographic presence to access emerging markets, and building strong customer relationships that create switching costs beyond price considerations.
For investors, the mycoplasma testing market offers attractive characteristics including mandatory, non-discretionary demand driven by regulatory requirements, sustainable growth tied to expanding biologics and cell therapy markets, relatively healthy margins supported by technical complexity and value-based purchasing, and market consolidation creating M&A opportunities. However, careful evaluation of specific investment opportunities should consider competitive positioning, customer concentration, technological differentiation, regulatory compliance track record, and management expertise in navigating the specialized requirements of biologics testing services.
Conclusion
Mycoplasma contamination represents a persistent challenge in biologic manufacturing that demands specialized testing services, creating a market opportunity at the intersection of regulatory requirements, technical complexity, and the expanding biologics industry. The unique characteristics of these organisms necessitate dedicated testing approaches distinct from traditional sterility testing, supporting a specialized services market with relatively healthy margins and sustainable growth drivers.
The market is evolving from traditional culture-based methods toward rapid molecular approaches, reshaping competitive dynamics and creating opportunities for service providers and technology companies positioned to meet changing customer needs. The explosive growth of cell and gene therapies is driving market expansion and premium pricing for rapid testing services aligned with compressed manufacturing timelines.
For technical professionals in biologics manufacturing, understanding mycoplasma testing requirements and available methods is essential for ensuring product quality and regulatory compliance. For business strategists and investors, the mycoplasma testing market represents a compelling opportunity in life sciences services, driven by mandatory regulatory requirements, favorable market dynamics, and sustained growth in underlying end markets.
Organizations that invest in robust testing capabilities, stay current with technological advances and regulatory evolution, and maintain focus on contamination prevention alongside detection will be best positioned to succeed whether as manufacturers ensuring product quality or as service providers capitalizing on market opportunities.

About The Author
Thomas Fraleigh has over 20 years of experience in the life sciences industry. His expertise spans manufacturing, quality control, regulatory and business development. He is the Founder and Principle Consultant for Terraforme Biosciences, working with investors and operators to change the life sciences landscape.
Published: 2025-March-27
Last Updated: 2025-March-27
Reading Time: 28 minutes
Interested In Learning More?
We help manufacturers with process controls, find partners for contract services and help investors evaluate new markets. Contact us to discuss mycoplasma testing considerations and investment opportunities.



